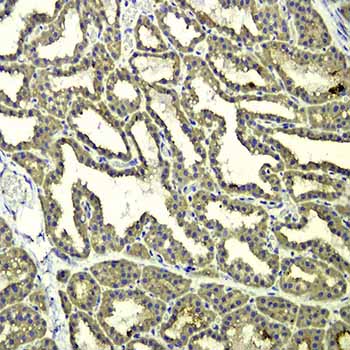

免疫组化(IHC)
- -
- 合肥麟美
- 安徽省合肥市
- 三个月以上
- 按需定制
- 议价
- 2022-12-02 14:10:35
合肥麟美生物科技有限公司
免疫组织化学又称免疫细胞化学,可以用于:(1)显色剂标记的特异性抗体在组织细胞原位通过抗原抗体反应和组织化学的呈色反应;(2)是对相应抗原进行定性、定位、定量测定的一项新技术。
一,免疫组织化学简介
免疫组织化学又称免疫细胞化学,是指带显色剂标记的特异性抗体在组织细胞原位通过抗原抗体反应和组织化学的呈色反应,对相应炕原进行定性、定位、定量测定的一项新技术。
它把免疫反应的特异性、组织化学的可见性巧妙地结合起来,借助显微镜( 包括荧光显微镜、电子显微镜) 的显像和放大作用,在细胞、亚细胞水平检测各种抗原物质( 如蛋白质、多肽、酶、激素、病原体以及受体等) 。
二,免疫组化技术的基本原理
免疫组化技术是一种综合定性、定位和定量;形态、机能和代谢密切结合为一体的研究和检测技术。在原位检测出病原的同时,还能观察到组织病变与该病原的关系,确认受染细胞类型,从而有助于了解疾病的发病机理和病理过程。
免疫酶组化技术是通过共价键将酶连接在抗体上,制成酶标抗体,再借酶对底物的特异催化作用,生成有色的不溶性产物或具有一定电子密度的颗粒,于普通显微镜或电镜下进行细胞表面及细胞内各种抗原成分的定位。
根据酶标记的部位可将其分为直接法(一步法)、间接法(二步法)、桥联法(多步法)等,用于标记的抗体可以是用免疫动物制备的多克隆抗体或特异性单克隆抗体,尽量是特异性强的效率高的价的单克隆抗体。
直接法是将酶直接标记在第一抗体上,间接法是将酶标记在第二抗体上,检测组织细胞内的特定抗原物质。目前通常选用免疫酶组化间接染色法。
三,免疫组化步骤
1, 切片,烤片60 ℃,1h ;
2 ,脱蜡及复水
二甲苯10min ,二甲苯10min ,100 %乙醇5min ,95 %乙醇5min ,90 %乙醇5min ,85 %乙醇5min ,80 %乙醇5min , 75 %乙醇5min ,60 %乙醇5min ,50 %乙醇5min ,30 %乙醇5min ,自来水1min ,双氧水1min ;
3 ,1 份30 %H2O2 加10 份蒸馏水,室温10min ,蒸馏水洗3 次,每次3min ;
4 ,微波修复
将切片浸入0.01M 枸橼酸缓冲液,微波中较大火力(98 ℃-100 ℃)加热至沸腾,冷却(约5-10min ),反复两次;
5 ,将切片自然冷却至室温,PBS 洗涤3 次,每次5min ;
6 ,封闭,5 %BSA ,室温20min ,甩去多余液体;
7 ,滴加一抗,37 ℃,1h ,或者4 ℃过夜;
8 ,PBS 洗涤3 次,每次3min ;
9 ,滴加二抗,37 ℃,15-30min ;
10 ,PBS 洗涤3 次,每次3min ;
11 ,滴加SABC ,37 ℃, 30min ;
12 ,PBS 洗涤3 次,每次5min ;
13 ,1ml 蒸馏水中分别滴加显色剂,混匀;
14 ,DAB 显色剂配置好后,滴加于切片,室温,镜下检测反应时间(约5min );
15 ,自来水冲洗干净,过蒸馏水;
16 ,苏木素复染2min ,自来水冲洗;
17 ,脱水
30 %乙醇3min ,50 %乙醇3min ,70 %乙醇3min ,80 %乙醇3min ,90 %乙醇3min ,95 %乙醇3min ,100 %乙醇3min ,二甲苯20min ;
18 ,树胶封片,镜检。
四,免疫组化常见问题分析
1 ,石蜡切片在染色过程中出现脱片现象
1 )烤片时间不够,或温度不够,可以延长烤片时间和提高烤片温度;
2 )用含有多聚赖氨酸的玻片,可以购买到或这自己做;
3 )有些组织本身就容易掉片,如骨组织等,操作时冲PBS 不要直接冲到组织上,冲到组织上方,让它流下冲洗组织;
4 )用高温修复时,温度骤冷也可能引起。
2 ,边缘效应
1 )组织边缘与玻片粘贴不牢,边缘组织松脱漂浮在液体中,每次清洗不易将组织下面试剂洗尽所致. 解决办法:制备优良的胶片(APES 或多聚赖氨酸),切出尽量薄的组织切片,不厚于4 微米,组织的前期处理应规范,尽量避免选用坏死较多的组织;
2 )切片上滴加的试剂未充分覆盖组织,边缘的试剂容易首先变干,浓度较中心组织高而致染色深。解决办法:试剂要充分覆盖组织,应超出组织边缘2mm 。用组化笔画圈时,为了避免油剂的影响,画圈应距组织边缘3-4mm 。
3 ,产生组织切片非特异性染色
1 )抗体孵育时间过长、抗体浓度高易增加背景着色。这可通过缩短一抗/ 二抗孵育时间、稀释抗体来控制。这是重要的一条;
2 )一抗用多克隆抗体易出现非特异性着色,建议试用单克隆抗体看看;
3 )内源性过氧化物酶和生物素在肝脏、肾脏等组织含量很高(含血细胞多的组织),需要通过延长灭活时间和增加灭活剂浓度来降低背景染色;
4 )非特异性组分与抗体结合,这需要通过延长二抗来源的动物免疫血清封闭时间和适当增加浓度来加强封闭效果;
5 )DAB 孵育时间过长或浓度过高;
6 )PBS 冲洗不充分,残留抗体结果增强着色,在一抗、二抗或SP 孵育之后的浸洗尤为重要;
7 )标本染色过程中经常出现干片,这容易增强非特异性着色。
4 ,免疫组化染色呈阴性结果
1 )抗体浓度和质量问题以及抗体来源选择错误;
2 )抗原修复不全,对于甲醛固定的组织须用充分抗原修复来打开抗原表位,以利于与抗体结合; 建议微波修复用高火4 次*6min 试试。有人做过实验,这是较佳的时间和次数。若不行,还可高压修复;
3 )组织切片本身这种抗原含量低;
4 )血清封闭时间过长;
5 )DAB 孵育时间过短;
6 )细胞通透不全,抗体未能充分进入胞内参与反应;
7 )开始做免疫组化,我建议你一定要首先做个阳性对照片,排除抗体等外的方法问题。
5 ,背景强
1, 考虑一抗浓度高;
2, 然后调整DAB 孵育时间;
3, 也要考虑血清封闭时间是否过短;
4, 适当增加抗体孵育后的浸洗次数和延长浸洗时间等

【一站式整体科研服务,成就更高水平的科研成果】
标书基金实验咨询 表观遗传组学分析
课题实验结题指导 细胞分子功能验证
实验培训文章润色 动物模型裸鼠成瘤
临床检测科研转化 病理染色分子互作
合作流程:














